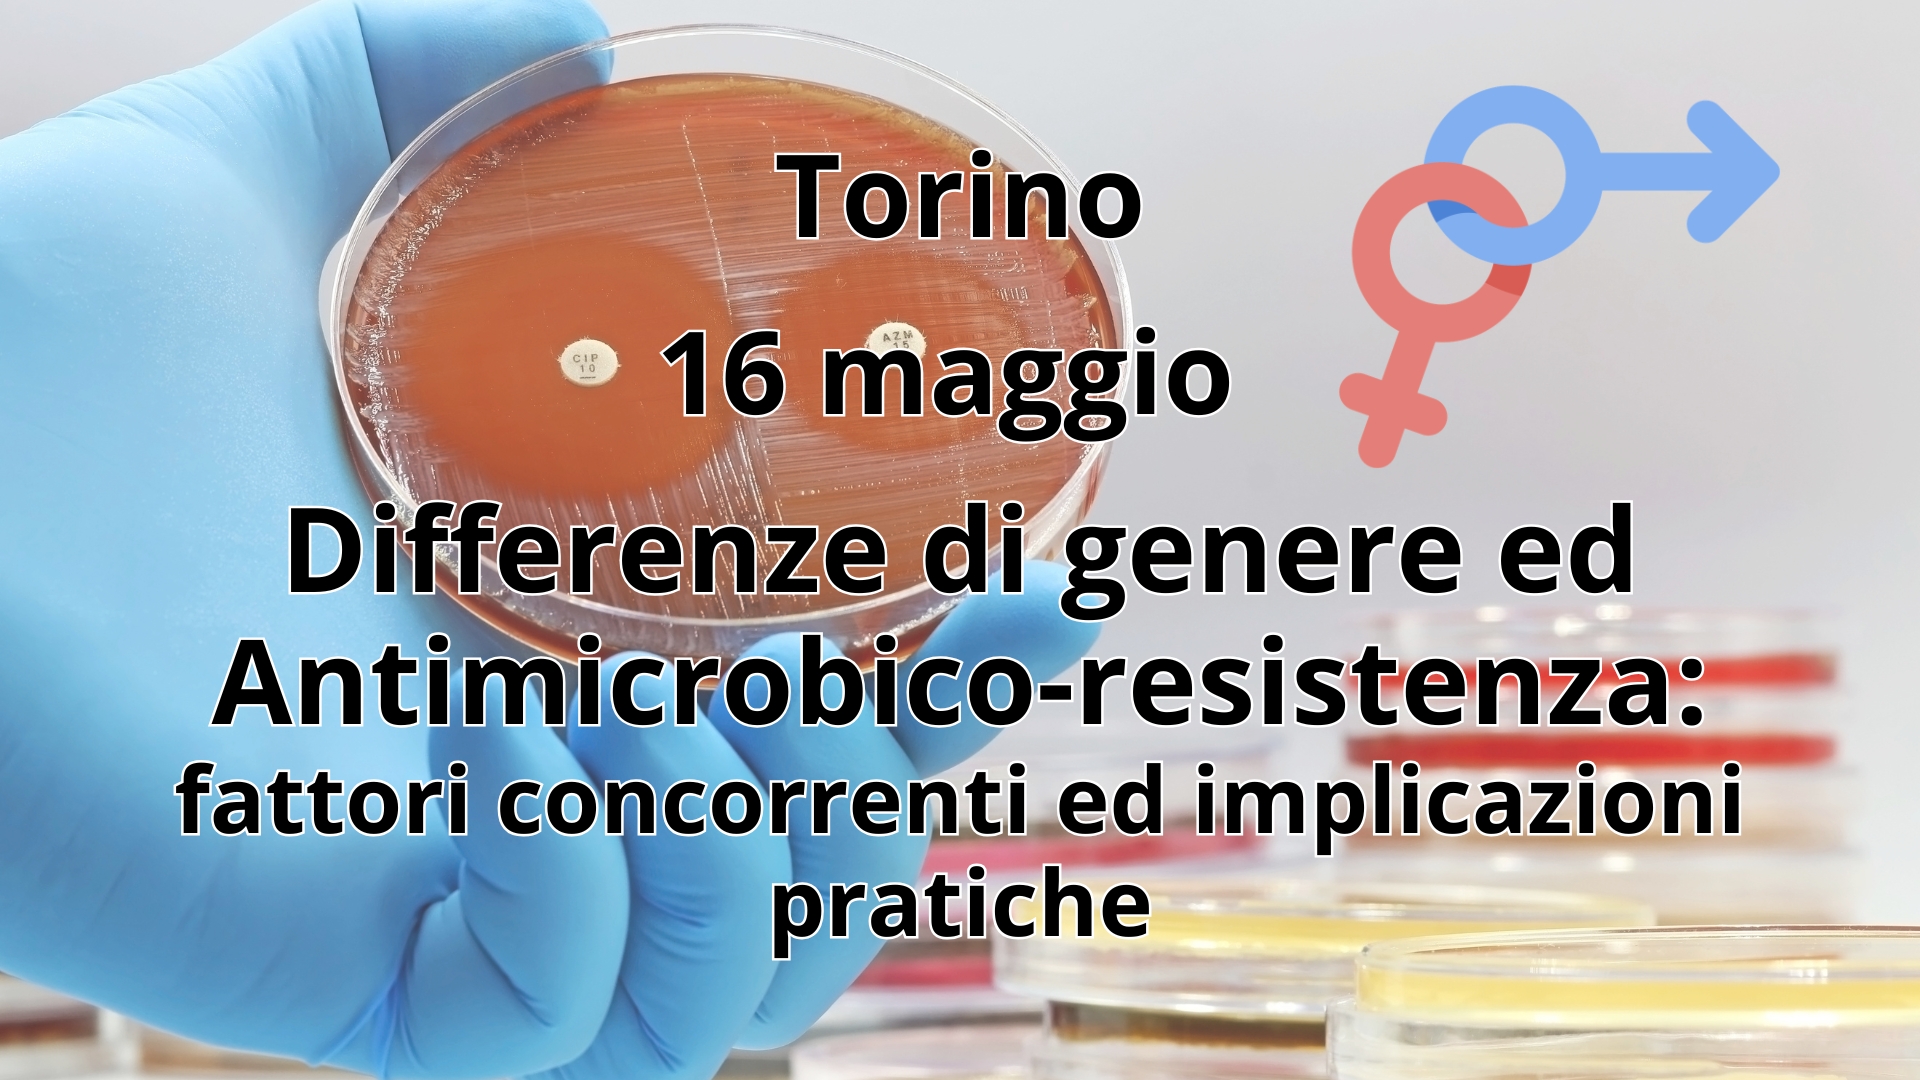
Clicca per accedere all'articolo Differenze di Genere e antimicrobico-resistenza: arriva a Torino un congresso per un approccio più mirato e consapevole

Aperto il concorso fotografico OdB PLV “Questo è un Lavoro da Biologi”
Raccontare la professione del Biologo attraverso un’immagine: è questo l’obiettivo del concorso fotografico “Questo è un Lavoro da Biologi”, promosso dall’Ordine dei Biologi del Piemonte, della Liguria e della Valle d’Aosta, e riservato a tutti gli iscritti e con iscrizione gratuita.
È arrivata la Biblioteca Digitale dell'Ordine dei Biologi del Piemonte, della Liguria e della Valle d'Aosta
Benvenuti nella Biblioteca Digitale dell'Ordine dei Biologi PLV!
A partire dal 2 aprile 2025, l'Ordine dei Biologi del Piemonte, della Liguria e della Valle d'Aosta ha inaugurato la sua Biblioteca Digitale, una risorsa moderna, gratuita per gli iscritti e pensata per supportare la formazione continua e il progresso professionale dei Biologi. Venite a scoprirla!